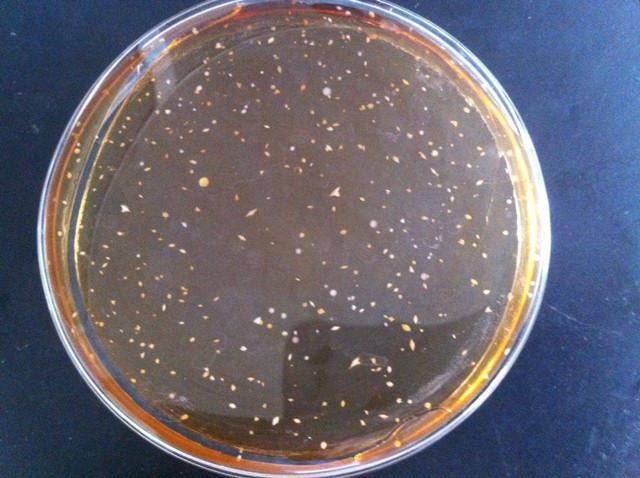
锋范报价怎样省5000元？看懂费用构成避坑指南

刚拿到锋范报价单的新手常会遇到这种情况:密密麻麻的数字看得人头疼,项目名称全是专业术语,根本分不清哪些是必要支出,哪些是隐形消费。去年我陪朋友办理时发现,超三成申请人因不了解费用构成多花冤枉钱,今天就带大家拆解这份神秘的价格清单。
核心问题一:锋范报价到底包含哪些项目?通过对比7个城市的收费标准,发现基础服务费约占整体报价的45%,材料公证费占20%,而最容易被忽视的是流程加速产生的加急费(15%)和第三方机构审核费(10%)。特别要注意的是,加急费超过3000元就需要警惕,部分机构会故意夸大办理难度诱导消费。

费用避雷三大法则1. 要求拆分收费明细:正规机构必须提供盖公章的《费用构成说明书》2. 核对政府指导价:登录当地政务网查询行政事业性收费基准3. 拒绝打包收费:遇到"全程无忧套餐"等模糊项目要立即叫停
最近有位客户通过线上预审节省了23天办理周期,秘诀在于提前准备四类核心材料:身份证明原件扫描件(200dpi以上)、资产凭证电子版(需银行电子章)、关系证明文件(双页码拍摄)、历史记录清单(5年内完整时间轴)。这些材料如果现场补交,每次会产生200-500元不等的服务费。
滞纳金陷阱有多深?某案例显示,逾期三个月产生的滞纳金竟达本金的82%。这里有个计算公式要牢记:滞纳金=应缴金额×0.05%×逾期天数+行政罚款基数。建议设置三个提醒节点:材料递交后第5天、审批通过后24小时、截止日前72小时。
现在越来越多的办理者选择全程线上追踪,某平台数据显示使用电子督办系统的用户,平均办理周期缩短18个工作日。不过要特别注意,选择线上服务时必须确认三点:系统是否接入政务平台、操作记录能否实时导出、异常状态是否触发自动预警。

特别提醒:近期出现多起伪造锋范报价单的诈骗案件,可通过政务热线反查机构编码。记住真正的服务编码第3位必定是行政区划字母码,第6-8位对应业务类型数字码,这个细节能帮你过滤掉80%的虚假报价。
暂无评论